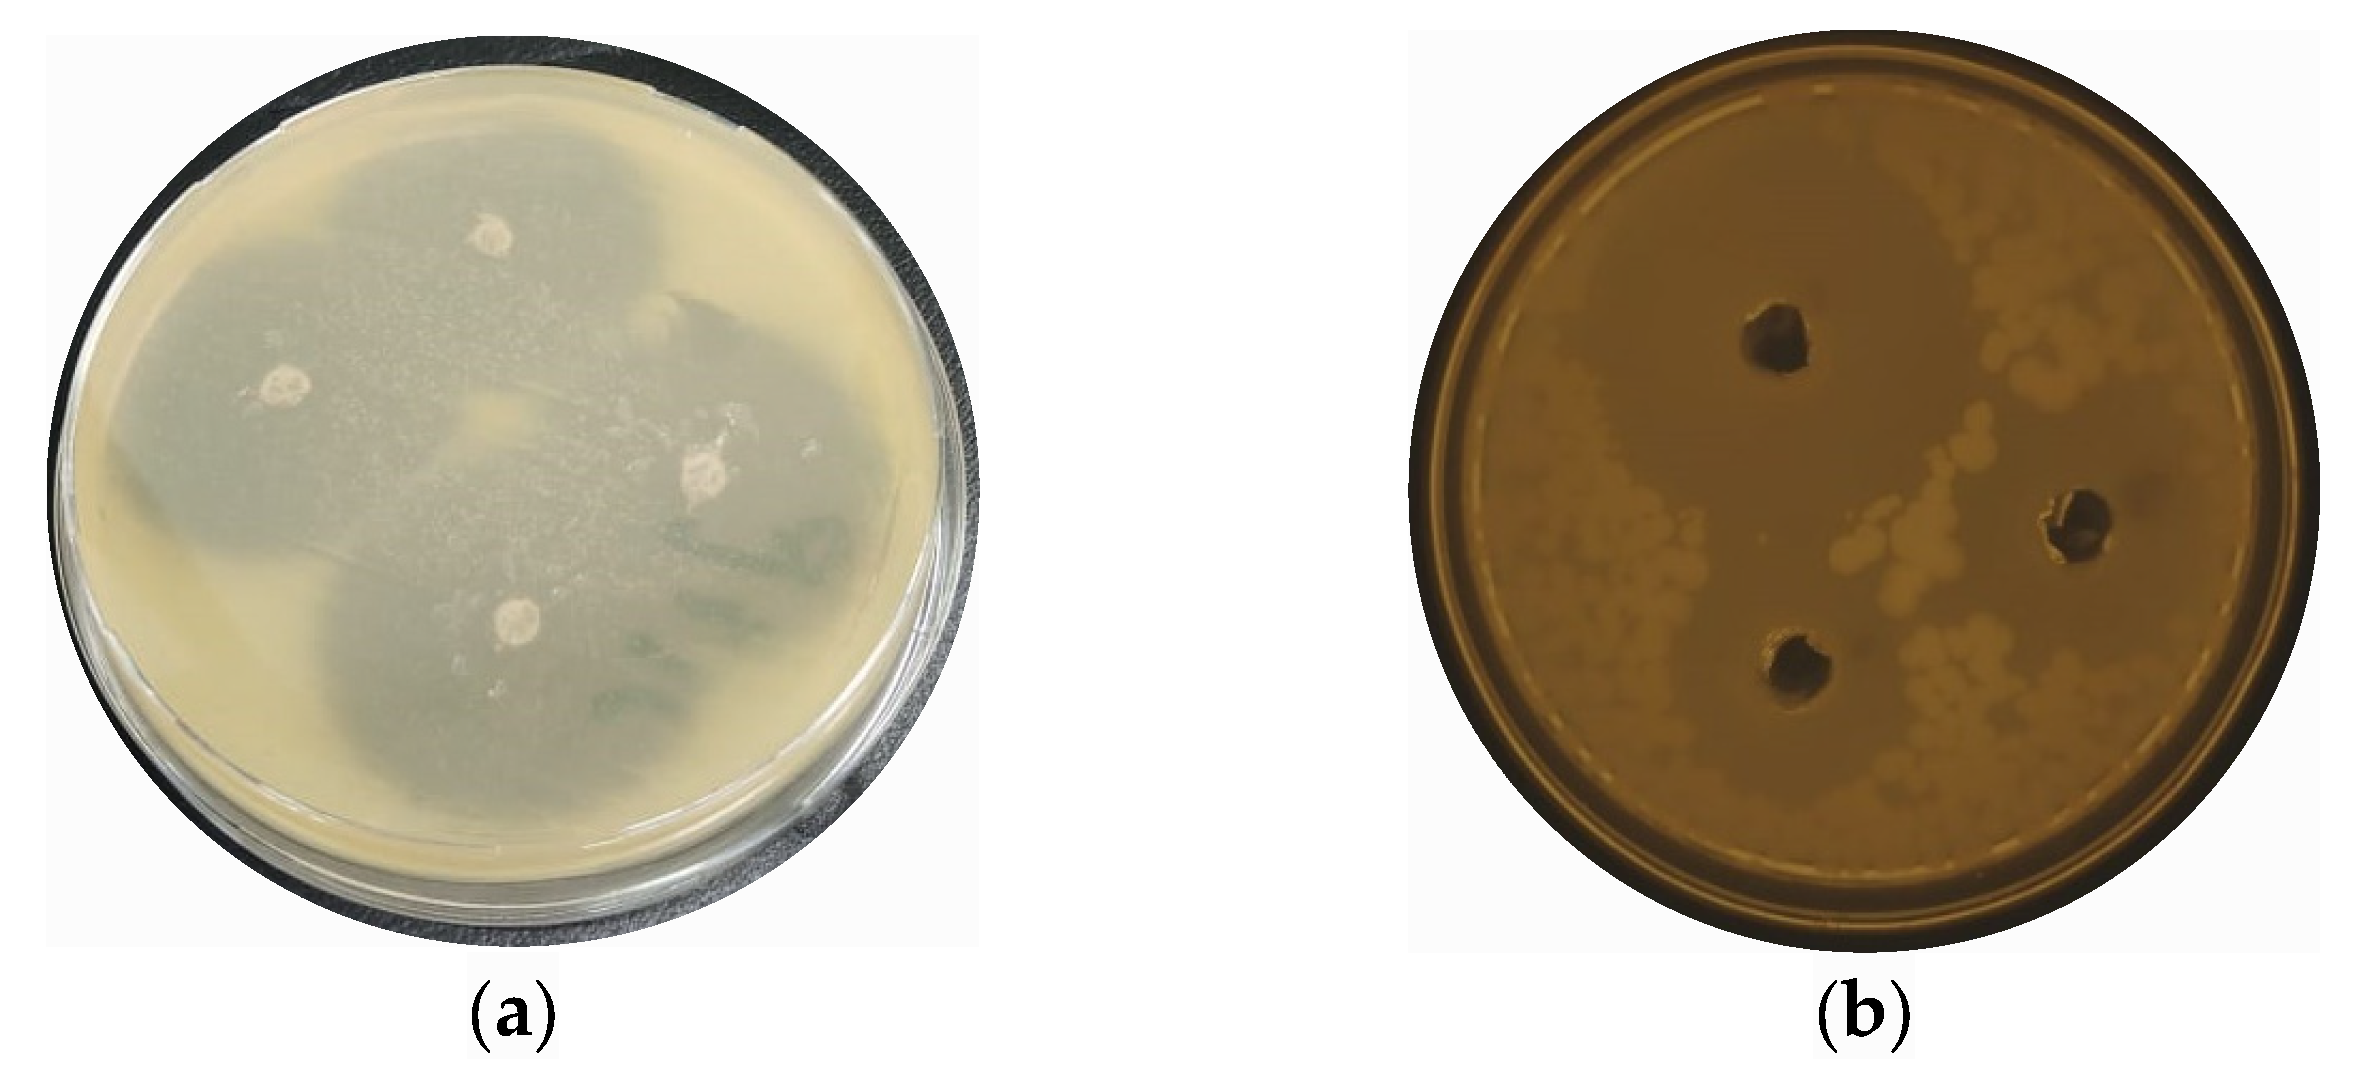
Molecules 28 05553 g004a Molecules 28 05553 g004a

Antibacterial and Antibiofilm Activity of Ficus carica-Mediated Calcium Oxide (CaONPs) Phyto-Nanoparticles
Abstract
1. Introduction
2. Results and Discussion
2.1. Plant-Extract Preparation and Biosynthesis of Calcium Oxide NPs
2.2. UV-Visible Spectroscopic Analysis
2.3. Fourier-Transform Infrared Spectroscopy (FTIR) Analysis
2.4. X-ray Powder Diffraction (XRD) Analysis
2.5. Energy-Dispersive X-ray Spectroscopy (EDX) Analysis
2.6. Scanning-Electron Microscopy (SEM) Analysis
2.7. Antibacterial Activities of CaONPs
2.8. Anti-Biofilm Activities of CaO NPs
3. Materials and Methods
3.1. Ficuscarica-Extract Preparation
3.2. Biosynthesis of Calcium Oxide NPs
3.3. Characterization of Biosynthesized Calcium Oxide NPs
3.4. Collection of Bacterial Samples
3.5. Antibacterial Efficacy of CaO-NPs established by Using Agar-Well-Diffusion Method
3.6. Statistical Analysis
4. Conclusions
Author Contributions
Funding
Institutional Review Board Statement
Informed Consent Statement
Data Availability Statement
Acknowledgments
Conflicts of Interest
Sample Availability
References
- Sharma, R.; Sharma, K.S.; Kumar, D. Introduction to Nanotechnology. In Nanomaterials in Clinical Therapeutics: Synthesis and Applications; Scrivener Publish: Beverly, MA, USA, 2022. [Google Scholar]
- Bayda, S.; Adeel, M.; Tuccinardi, T.; Cordani, M.; Rizzolio, F. The History of Nanoscience and Nanotechnology: From Chemical-Physical Applications to Nanomedicine. Molecules 2020, 25, 112. [Google Scholar] [CrossRef] [PubMed]
- Saadh, M.J.; Jadullah, R.K. Nanotechnology in Drug Delivery. Pharmacologyonline 2021, 3, 1129–1135. [Google Scholar] [CrossRef]
- Chakravarty, M.; Vora, A. Nanotechnology-Based Antiviral Therapeutics. Drug Deliv. Transl. Res. 2021, 11, 748–787. [Google Scholar] [CrossRef] [PubMed]
- Saritha, G.N.G.; Anju, T.; Kumar, A. Nanotechnology—Big Impact: How Nanotechnology Is Changing the Future of Agriculture? J. Agric. Food Res. 2022, 10, 100457. [Google Scholar] [CrossRef]
- Sharma, D.; Kanchi, S.; Bisetty, K. Biogenic Synthesis of Nanoparticles: A Review. Arab. J. Chem. 2019, 12, 3576–3600. [Google Scholar] [CrossRef]
- Gour, A.; Jain, N.K. Advances in Green Synthesis of Nanoparticles. Artif. Cells Nanomed. Biotechnol. 2019, 47, 844–851. [Google Scholar] [CrossRef] [PubMed]
- Jadoun, S.; Arif, R.; Jangid, N.K.; Meena, R.K. Green Synthesis of Nanoparticles Using Plant Extracts: A Review. Environ. Chem. Lett. 2021, 19, 355–374. [Google Scholar] [CrossRef]
- Naikoo, G.A.; Mustaqeem, M.; Hassan, I.U.; Awan, T.; Arshad, F.; Salim, H.; Qurashi, A. Bioinspired and Green Synthesis of Nanoparticles from Plant Extracts with Antiviral and Antimicrobial Properties: A Critical Review. J. Saudi Chem. Soc. 2021, 25, 101304. [Google Scholar] [CrossRef]
- Zhang, D.; Ma, X.L.; Gu, Y.; Huang, H.; Zhang, G.W. Green Synthesis of Metallic Nanoparticles and Their Potential Applications to Treat Cancer. Front. Chem. 2020, 8, 799. [Google Scholar] [CrossRef]
- Khan, F.; Shahid, A.; Zhu, H.; Wang, N.; Javed, M.R.; Ahmad, N.; Xu, J.; Alam, M.A.; Mehmood, M.A. Prospects of Algae-Based Green Synthesis of Nanoparticles for Environmental Applications. Chemosphere 2022, 293, 134465. [Google Scholar] [CrossRef]
- Ying, S.; Guan, Z.; Ofoegbu, P.C.; Clubb, P.; Rico, C.; He, F.; Hong, J. Green Synthesis of Nanoparticles: Current Developments and Limitations. Environ. Technol. Innov. 2022, 26, 102336. [Google Scholar] [CrossRef]
- Rakshit, S.; Jana, P.C.; Kamilya, T. Green Synthesis of Copper Nanoparticles by Using Plant Extracts and Their Biomedical Applications—An Extensive Review. Curr. Nanomater. 2022, 8, 110–125. [Google Scholar] [CrossRef]
- Sokolova, V.; Epple, M. Biological and Medical Applications of Calcium Phosphate Nanoparticles. Chem. A Eur. J. 2021, 27, 7471–7488. [Google Scholar] [CrossRef] [PubMed]
- Morovati, M.R.; Ghanbari-Movahed, M.; Barton, E.M.; Farzaei, M.H.; Bishayee, A. A Systematic Review on Potential Anticancer Activities of Ficus carica L. with Focus on Cellular and Molecular Mechanisms. Phytomedicine 2022, 105, 154333. [Google Scholar] [CrossRef] [PubMed]
- Shivaprasad, H.V.; Rajesh, R.; Yariswamy, M.; Vishwanath, B.S. Procoagulant Properties of Plant Latex Proteases. In Toxins and Hemostasis: From Bench to Bedside; Springer Nature: Berlin/Heidelberg, Germany, 2011. [Google Scholar]
- Khan Marwa, S.; Aslam Khan, M.; ur-Rehman, F.-; Ullah Bhat, I. Aromatic Plant Species Mentioned in the Holy Qura’n and Ahadith and Their Ethnomedicinal Importance. Pak. J. Nutr. 2009, 8, 1472–1479. [Google Scholar] [CrossRef]
- Debib, A.; Tir-Touil, A.; Mothana, R.A.; Meddah, B.; Sonnet, P. Phenolic Content, Antioxidant and Antimicrobial Activities of Two Fruit Varieties of Algerian Ficus carica L. J. Food Biochem. 2014, 38, 207–215. [Google Scholar] [CrossRef]
- Maringgal, B.; Hashim, N.; Tawakkal, I.S.M.A.; Hamzah, M.H.; Mohamed, M.T.M. Biosynthesis of CaO Nanoparticles Using Trigona Sp. Honey: Physicochemical Characterization, Antifungal Activity, and Cytotoxicity Properties. J. Mater. Res. Technol. 2020, 9, 11756–11768. [Google Scholar] [CrossRef]
- Paramanya, A.; Patel, N.; Kumar, D.; Kamal, F.Z.; Yiğit, B.M.; Sundarrajan, P.; Balyan, P.; Khan, J.; Ali, A. Preventive Roles of Phytochemicals from Ficus carica in Diabetes and Its Secondary Complications. In Fig (Ficus carica): Production, Processing, and Properties; Springer Nature: Berlin/Heidelberg, Germany, 2023; pp. 539–559. [Google Scholar] [CrossRef]
- Shirazi, M.S.; Farimani, M.M.; Reports, A.F.-S. undefined Bioengineered Synthesis of Phytochemical-Adorned Green Silver Oxide (Ag2O) Nanoparticles via Mentha Pulegium and Ficus carica Extracts with High antioxidant, antibacterial, and antifungal activities. Sci. Rep. 2022, 12, 21509. [Google Scholar] [CrossRef]
- Hara, N. Uv-Visible Spectroscopy. Zair. Kankyo 1993, 42, 529–538. [Google Scholar] [CrossRef]
- Picollo, M.; Aceto, M.; Vitorino, T. UV-Vis Spectroscopy. Phys. Sci. Rev. 2019, 4, 20180008. [Google Scholar] [CrossRef]
- Gandhi, N.; Shruthi, Y.; Sirisha, G.; Anusha, C.R. Undefined Facile and Eco-Friendly Method for Synthesis of Calcium Oxide (CaO) Nanoparticles and Its Potential Application in Agriculture. Saudi J. Life Sci. 2021, 6, 89–103. [Google Scholar]
- Langmuir, P.M. Undefined Surface Plasmon Spectroscopy of Nanosized Metal Particles; ACS Publications: Washington, DC, USA, 1996. [Google Scholar]
- Garg, R.; Kumari, M.; Kumar, M.; Dhiman, S.; Garg, R. Green Synthesis of Calcium Carbonate Nanoparticles Using Waste Fruit Peel Extract. Proc. Mater. Today Proc. 2020, 46, 6665–6668. [Google Scholar] [CrossRef]
- Qi, C.; Musetti, S.; Fu, L.H.; Zhu, Y.J.; Huang, L. Biomolecule-Assisted Green Synthesis of Nanostructured Calcium Phosphates and Their Biomedical Applications. Chem. Soc. Rev. 2019, 48, 2698–2737. [Google Scholar] [CrossRef] [PubMed]
- Roy, A.; Nanoscience, J.B.-I.J. Undefined Microwave-Assisted Synthesis and Characterization of CaO Nanoparticles; World Scientific: Singapore, 2012. [Google Scholar] [CrossRef]
- Jalu, R.; Chamada, T.; Challenges, R.K.-E. Undefined Calcium Oxide Nanoparticles Synthesis from Hen Eggshells for Removal of Lead (Pb (II)) from Aqueous Solution; Elsevier: Amsterdam, The Netherlands, 2021. [Google Scholar]
- Shlyakhova, E.V.; Bulusheva, L.G.; Kanygin, M.A.; Plyusnin, P.E.; Kovalenko, K.A.; Senkovskiy, B.V.; Okotrub, A. V Synthesis of Nitrogen-containing Porous Carbon Using Calcium Oxide Nanoparticles. Wiley Online Libr. 2014, 251, 2607–2612. [Google Scholar] [CrossRef]
- Roy, A.; Bhattacharya, J. Microwave-Assisted Synthesis and Characterization of CaO Nanoparticles. Int. J. Nanosci. 2011, 10, 413–418. [Google Scholar] [CrossRef]
- Anantharaman, A.; Ramalakshmi, S.; Appl, M.G. Undefined Green Synthesis of Calcium Oxide Nanoparticles and Its Applications. Int. J. Eng. Res. 2016, 6, 27–31. [Google Scholar]
- Osuntokun, J.; Onwudiwe, D.C.; Ebenso, E.E. Aqueous Extract of Broccoli Mediated Synthesis of CaO Nanoparticles and Its Application in the Photocatalytic Degradation of Bromocrescol Green. Wiley Online Libr. 2018, 12, 888–894. [Google Scholar] [CrossRef]
- Marouzi, S.; Sabouri, Z.; International, M.D.-C. Undefined Greener Synthesis and Medical Applications of Metal Oxide Nanoparticles; Elsevier: Amsterdam, The Netherlands, 2021. [Google Scholar]
- Patel, G.; Pal, U.; Menon, S. Removal of Fluoride from Aqueous Solution by CaO Nanoparticles. Sep. Sci. Technol. 2009, 44, 2806–2826. [Google Scholar] [CrossRef]
- Butt, A.R.; Ejaz, S.; Baron, J.C.; Ikram, M.; Ali, S. Undefined CaO Nanoparticles as a Potential Drug Delivery Agent for Biomedical Applications. Res. Net. 2012, 47, 471–478. [Google Scholar] [CrossRef]
- Asghar, M.A.; Asghar, M.A. Green Synthesized and Characterized Copper Nanoparticles Using Various New Plants Extracts Aggravate Microbial Cell Membrane Damage after Interaction with Lipopolysaccharide. Int. J. Biol. Macromol. 2020, 160, 1168–1176. [Google Scholar] [CrossRef]
- Ijaz, U.; Bhatti, I.A.; Mirza, S.; Ashar, A. Characterization and Evaluation of Antibacterial Activity of Plant Mediated Calcium Oxide (CaO) Nanoparticles by Employing Mentha Pipertia Extract. Mater. Res. Express 2017, 4, 105402. [Google Scholar] [CrossRef]
- Murthy, P.S.; Pandiyan, V.; Das, A. Potential of Metal Oxide Nanoparticles and Nanocomposites as Antibiofilm Agents: Leverages and Limitations. Nanotechnol. Life Sci. 2022, 163–209. [Google Scholar] [CrossRef]
- Muhammad, M.H.; Idris, A.L.; Fan, X.; Guo, Y.; Yu, Y.; Jin, X.; Qiu, J.; Guan, X.; Huang, T. Beyond Risk: Bacterial Biofilms and Their Regulating Approaches. Front. Microbiol. 2020, 11, 928. [Google Scholar] [CrossRef] [PubMed]
- Thi, M.T.T.; Wibowo, D.; Rehm, B.H.A. Pseudomonas Aeruginosa Biofilms. Int. J. Mol. Sci. 2020, 21, 8671. [Google Scholar] [CrossRef]
- Azeredo, J.; Azevedo, N.F.; Briandet, R.; Cerca, N.; Coenye, T.; Costa, A.R.; Desvaux, M.; Di Bonaventura, G.; Hébraud, M.; Jaglic, Z.; et al. Critical Review on Biofilm Methods. Crit. Rev. Microbiol. 2017, 43, 313–351. [Google Scholar] [CrossRef]
- Hu, C.; Wang, L.L.; Lin, Y.Q.; Liang, H.M.; Zhou, S.Y.; Zheng, F.; Feng, X.L.; Rui, Y.Y.; Shao, L.Q. Nanoparticles for the Treatment of Oral Biofilms: Current State, Mechanisms, Influencing Factors, and Prospects. Adv. Healthc. Mater. 2019, 8, e1901301. [Google Scholar] [CrossRef]
- Shkodenko, L.; Kassirov, I.; Koshel, E. Metal Oxide Nanoparticles against Bacterial Biofilms: Perspectives and Limitations. Microorganisms 2020, 8, 1545. [Google Scholar] [CrossRef]
- Li, C.; Cornel, E.J.; Du, J. Advances and Prospects of Polymeric Particles for the Treatment of Bacterial Biofilms. ACS Appl. Polym. Mater. 2021, 3, 2218–2232. [Google Scholar] [CrossRef]
- Leng, D.; Li, Y.; Zhu, J.; Liang, R.; Zhang, C.; Zhou, Y.; Li, M.; Wang, Y.; Rong, D.; Wu, D.; et al. The Antibiofilm Activity and Mechanism of Nanosilver-and Nanozinc-Incorporated Mesoporous Calcium-Silicate Nanoparticles. Int. J. Nanomed. 2020, 15, 3921–3936. [Google Scholar] [CrossRef]
- Kang, M.G.; Khan, F.; Jo, D.M.; Oh, D.K.; Tabassum, N.; Kim, Y.M. Antibiofilm and Antivirulence Activities of Gold and Zinc Oxide Nanoparticles Synthesized from Kimchi-Isolated Leuconostoc Sp. Strain C2. Antibiotics 2022, 11, 1524. [Google Scholar] [CrossRef]
- Qayyum, S.; Khan, A.U. Nanoparticles: Vs. Biofilms: A Battle against Another Paradigm of Antibiotic Resistance. Medchemcomm 2016, 7, 1479–1498. [Google Scholar] [CrossRef]
- Das, P.; Ghosh, S.; Nayak, B. Phyto-Fabricated Nanoparticles and Their Anti-Biofilm Activity: Progress and Current Status. Front. Nanotechnol. 2021, 3, 739286. [Google Scholar] [CrossRef]
- Abdullahi; Hussain, T.; Faisal, S.; Rizwan, M.; Saira; Zaman, N.; Iqbal, M.; Iqbal, A.; Ali, Z. Green Synthesis and Characterization of Copper and Nickel Hybrid Nanomaterials: Investigation of Their Biological and Photocatalytic Potential for the Removal of Organic Crystal Violet Dye. J. Saudi Chem. Soc. 2022, 26, 101486. [Google Scholar] [CrossRef]
- Azmi, S.N.H.; Al Lawati, W.M.; Al Hoqani, U.H.A.; Al Aufi, E.; Al Hatmi, K.; Al Zadjali, J.S.; Rahman, N.; Nasir, M.; Rahman, H.; Khan, S.A. Development of a Citric-Acid-Modified Cellulose Adsorbent Derived from Moringa Peregrina Leaf for Adsorptive Removal of Citalopram HBr in Aqueous Solutions. Pharmaceuticals 2022, 15, 760. [Google Scholar] [CrossRef]
- Abdullah; Al-Radadi, N.S.; Hussain, T.; Faisal, S.; Ali Raza Shah, S. Novel Biosynthesis, Characterization and Bio-Catalytic Potential of Green Algae (Spirogyra Hyalina) Mediated Silver Nanomaterials. Saudi J. Biol. Sci. 2022, 29, 411–419. [Google Scholar] [CrossRef]
- Faisal, S.; Jan, H.; Abdullah; Alam, I.; Rizwan, M.; Hussain, Z.; Sultana, K.; Ali, Z.; Uddin, M.N. In Vivo Analgesic, Anti-Inflammatory, and Anti-Diabetic Screening of Bacopa Monnieri-Synthesized Copper Oxide Nanoparticles. ACS Omega 2022, 7, 4071–4082. [Google Scholar] [CrossRef]
- Azmi, S.N.H.; Al-Jassasi, B.M.H.; Al-Sawafi, H.M.S.; Al-Shukaili, S.H.G.; Rahman, N.; Nasir, M. Optimization for Synthesis of Silver Nanoparticles through Response Surface Methodology Using Leaf Extract of Boswellia Sacra and Its Application in Antimicrobial Activity. Environ. Monit. Assess. 2021, 193, 1–16. [Google Scholar] [CrossRef]
- Mumtaz, S.; Mumtaz, S.; Ali, S.; Tahir, H.M.; Kazmi, S.A.R.; Mughal, T.A.; Younas, M. Evaluation of Antibacterial Activity of Vitamin C against Human Bacterial Pathogens. Braz. J. Biol. 2023, 83, e247165. [Google Scholar] [CrossRef]
- El-Baz, A.M.; Yahya, G.; Mansour, B.; El-Sokkary, M.M.A.; Alshaman, R.; Alattar, A.; El-Ganiny, A.M. The Link between Occurrence of Class i Integron and Acquired Aminoglycoside Resistance in Clinical Mrsa Isolates. Antibiotics 2021, 10, 488. [Google Scholar] [CrossRef]
- El-Telbany, M.; Mohamed, A.A.; Yahya, G.; Abdelghafar, A.; Abdel-Halim, M.S.; Saber, S.; Alfaleh, M.A.; Mohamed, A.H.; Abdelrahman, F.; Fathey, H.A.; et al. Combination of Meropenem and Zinc Oxide Nanoparticles; Antimicrobial Synergism, Exaggerated Antibiofilm Activity, and Efficient Therapeutic Strategy against Bacterial Keratitis. Antibiotics 2022, 11, 1374. [Google Scholar] [CrossRef]
- Yahya, G.; Ebada, A.; Khalaf, E.M.; Mansour, B.; Nouh, N.A.; Mosbah, R.A.; Saber, S.; Moustafa, M.; Negm, S.; El-Sokkary, M.M.A.; et al. Soil-Associated Bacillus Species: A Reservoir of Bioactive Compounds with Potential Therapeutic Activity against Human Pathogens. Microorganisms 2021, 9, 1131. [Google Scholar] [CrossRef]
- Fekry, M.; Yahya, G.; Osman, A.; Al-Rabia, M.W.; Mostafa, I.; Abbas, H.A. GC-MS Analysis and Microbiological Evaluation of Caraway Essential Oil as a Virulence Attenuating Agent against Pseudomonas Aeruginosa. Molecules 2022, 27, 8532. [Google Scholar] [CrossRef] [PubMed]
- Abdel-Halim, M.S.; Askoura, M.; Mansour, B.; Yahya, G.; El-Ganiny, A.M. In Vitro Activity of Celastrol in Combination with Thymol against Carbapenem-Resistant Klebsiella Pneumoniae Isolates. J. Antibiot. 2022, 75, 679–690. [Google Scholar] [CrossRef] [PubMed]
- Baiomy, A.A.; Serry, F.E.; Kadry, A.A.; Yahya, G.; Doijad, S.; Mostafa, A.; Mraheil, M.A.; El-Ganiny, A.M. Genome Analysis of Pseudomonas Aeruginosa Strains from Chronically Infected Patients with High Levels of Persister Formation. Pathogens 2023, 12, 426. [Google Scholar] [CrossRef] [PubMed]
- Paunova-Krasteva, T.; Hemdan, B.A.; Dimitrova, P.D.; Damyanova, T.; El-Feky, A.M.; Elbatanony, M.M.; Stoitsova, S.; El-Liethy, M.A.; El-Taweel, G.E.; El Nahrawy, A.M. Hybrid Chitosan/CaO-Based Nanocomposites Doped with Plant Extracts from Azadirachta Indica and Melia Azedarach: Evaluation of Antibacterial and Antibiofilm Activities. Bionanoscience 2023, 13, 88–102. [Google Scholar] [CrossRef]

| Bacteria | OD at 570 nm | Percentage Inhibition of Biofilm by CaONPs |
|---|---|---|
| P. aeruginosa | 0.326 | 99 ± 1.4 |
| S. aureus | 0.468 | 98 ± 0.3 |
| K. pneumoniae | 0.767 | 79 ± 0.9 |
| P. vulgaris | 1.169 | 67 ± 0.9 |
| E. coli | 1.221 | 61 ± 1.6 |
| Growth Control | 2.181 |
Disclaimer/Publisher’s Note: The statements, opinions and data contained in all publications are solely those of the individual author(s) and contributor(s) and not of MDPI and/or the editor(s). MDPI and/or the editor(s) disclaim responsibility for any injury to people or property resulting from any ideas, methods, instructions or products referred to in the content. |
© 2023 by the authors. Licensee MDPI, Basel, Switzerland. This article is an open access article distributed under the terms and conditions of the Creative Commons Attribution (CC BY) license (https://creativecommons.org/licenses/by/4.0/).
Share and Cite
Khan, A.U.; Hussain, T.; Abdullah; Khan, M.A.; Almostafa, M.M.; Younis, N.S.; Yahya, G. Antibacterial and Antibiofilm Activity of Ficus carica-Mediated Calcium Oxide (CaONPs) Phyto-Nanoparticles. Molecules 2023, 28, 5553. https://doi.org/10.3390/molecules28145553
Khan AU, Hussain T, Abdullah, Khan MA, Almostafa MM, Younis NS, Yahya G. Antibacterial and Antibiofilm Activity of Ficus carica-Mediated Calcium Oxide (CaONPs) Phyto-Nanoparticles. Molecules. 2023; 28(14):5553. https://doi.org/10.3390/molecules28145553
Chicago/Turabian StyleKhan, Asif Ullah, Tahir Hussain, Abdullah, Mubarak Ali Khan, Mervt M. Almostafa, Nancy S. Younis, and Galal Yahya. 2023. "Antibacterial and Antibiofilm Activity of Ficus carica-Mediated Calcium Oxide (CaONPs) Phyto-Nanoparticles" Molecules 28, no. 14: 5553. https://doi.org/10.3390/molecules28145553
APA StyleKhan, A. U., Hussain, T., Abdullah, Khan, M. A., Almostafa, M. M., Younis, N. S., & Yahya, G. (2023). Antibacterial and Antibiofilm Activity of Ficus carica-Mediated Calcium Oxide (CaONPs) Phyto-Nanoparticles. Molecules, 28(14), 5553. https://doi.org/10.3390/molecules28145553

